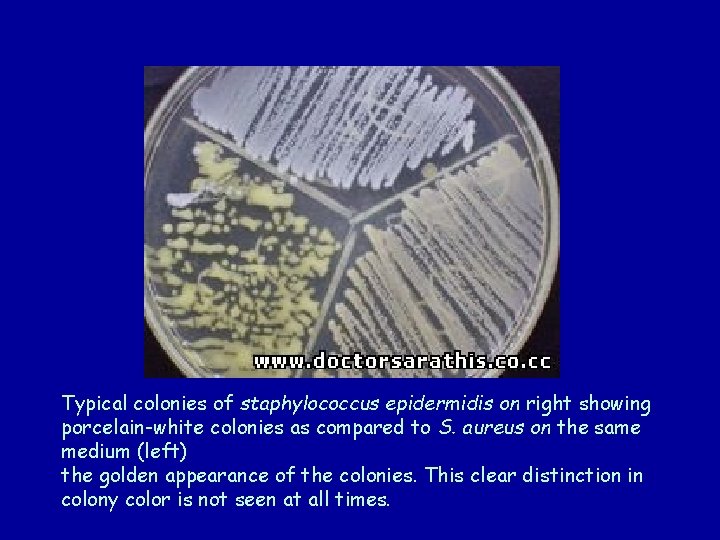
Typical colonies of staphylococcus epidermidis on right showing porcelain-white colonies as compared to S.
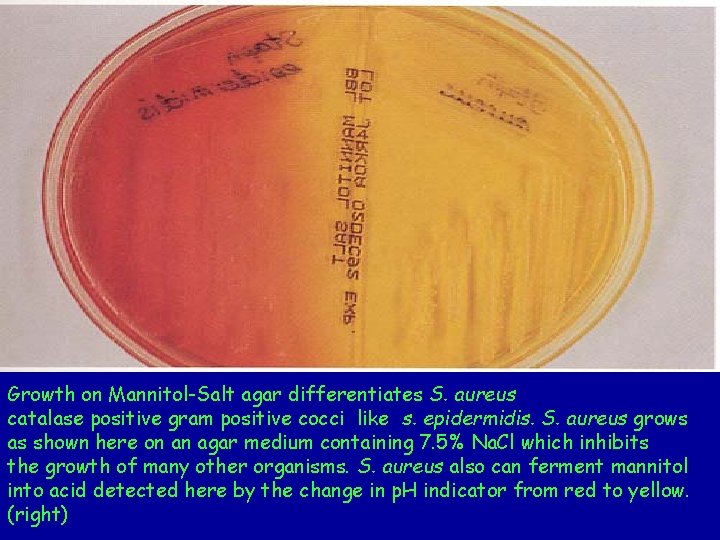
Growth on Mannitol-Salt agar differentiates S. aureus catalase positive gram positive cocci like s.
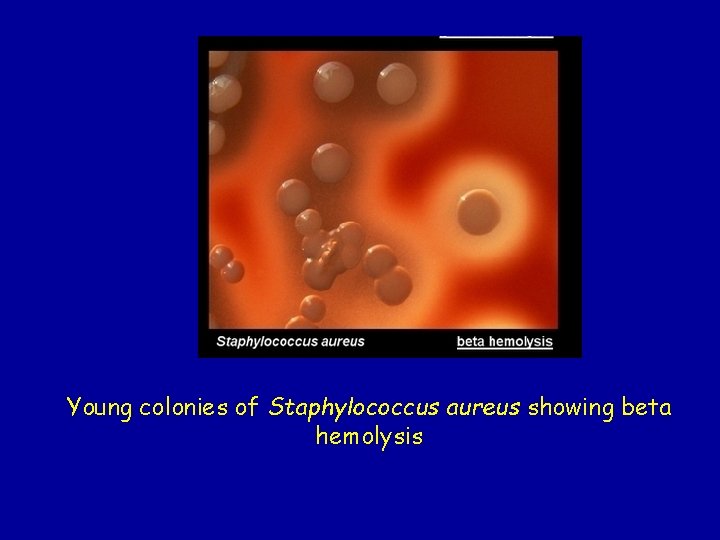
Young colonies of Staphylococcus aureus showing beta hemolysis
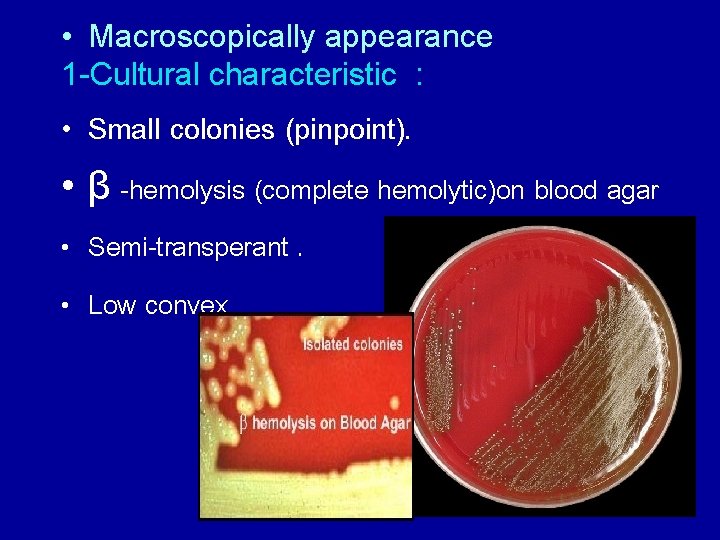
• Macroscopically appearance 1 -Cultural characteristic : • Small colonies (pinpoint). • β
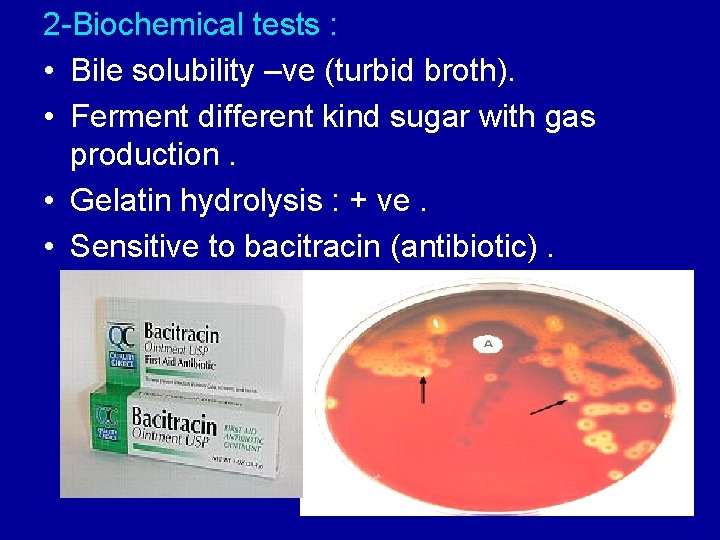
2 -Biochemical tests : • Bile solubility –ve (turbid broth). • Ferment different kind
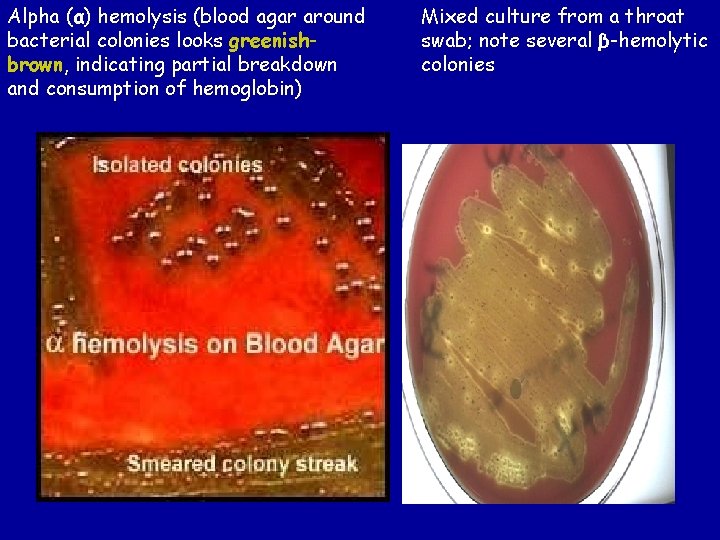
Alpha (α) hemolysis (blood agar around bacterial colonies looks greenishbrown, indicating partial breakdown and
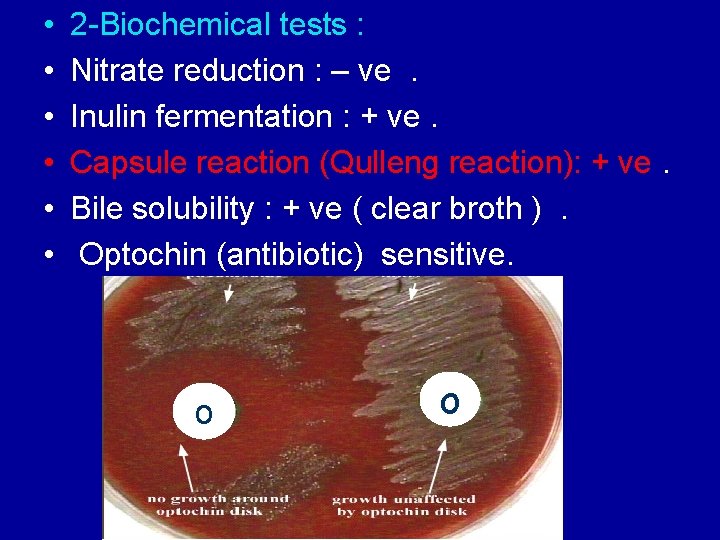
• • • 2 -Biochemical tests : Nitrate reduction : – ve. Inulin

Lab 7 Gram Positive Cocci Staphylococcus Streptococcus Gram

Lab : 7 Gram Positive Cocci Staphylococcus Streptococcus Gram Negative Cocci Neisseria

Staphylococci includes at least 40 species. Most are harmless and reside normally on the skin and mucous membranes of humans and other organisms. also they are a small component of soil microbial flora. Three species of staphylococci have medical importance : 1 - S. aureus : pathogenic & occasionally commensally found in nose. 2 - S. epidermidis(albus): non pathogenic & commensals in skin. 3 - S. saprophyticus (citrus): cause UTI in female & occasionally commensally found in skin.

General characters Microscopical appearance • G+ cocci • Arranged in cluster (Grape – like). • Non motile • Non spore forming • Non capsulated Macroscopically appearance 1 -Cultural characteristic: • Grow on most type of media and produce large (2 mm) smooth. • Opaque. Circular colonies. • Highly tolerate to high concentration of Na. Cl • Non fastidious, Facultative anaerobic. 2 - Biochemical tests : • Carbohydrate Fermentative without gas production. • Catalase positive. • Urease positive. • Nitrate reductase positive.

- + Staphylococci can be differentiated from other aerobic gram positive cocci by a positive catalase test. The test is performed by adding bacterial cells from a colony to a drop of 3% hydrogen peroxide. The appearance of bubbles (right) indicates the enzyme catalase while catalase negative bacteria give no reaction (left).

Staphylococcus aurous • Characteres • Microscopically appearance: as above. • Macroscopically appearance 1 -Cultural characteristic: • * Golden colonies on nutrient agar. • * Ferment mannitol. • * Β-hemolytic on blood agar. 2 -Biochemical tests : • • • * Production of coagulase. * Gelatin liquefied ( hydrolysis ). Novobiocin sensitivity. Production of phosphatase. Production of DNase.
Typical colonies of staphylococcus epidermidis on right showing porcelain-white colonies as compared to S. aureus on the same medium (left) the golden appearance of the colonies. This clear distinction in colony color is not seen at all times.
Growth on Mannitol-Salt agar differentiates S. aureus catalase positive gram positive cocci like s. epidermidis. S. aureus grows as shown here on an agar medium containing 7. 5% Na. Cl which inhibits the growth of many other organisms. S. aureus also can ferment mannitol into acid detected here by the change in p. H indicator from red to yellow. (right)
Young colonies of Staphylococcus aureus showing beta hemolysis

Coagulase test : 1 - Slide Coagulase test. The most important distinction among staphylococci is whether or not they produce the enzyme coagulase. S. aureus is the most common pathogen among the catalase positive gram positive cocci and is differentiated from other staphylococci by the coagulase test. Cogulase acts on fibrinogen and causes the clumping of the bacteria (right).

2 - Tube Coagulase test. The tube coagulase test detects both free and cell bound coagulase of S. aureus. . Coagulase acts on prothrombin and fibrinogen in plasma and forms a fibrin clot (left). + -

Novobiocin sensitivity test: S. Saprophyticus can be distinguished from other species of coagulase negative staphylococci by their resistance to novobiocin (right). The novobiocin susceptible staphylococcus is on the left.

S. aureus S. epidermidis (albus) S. saprophyticus (citrus) Catalase test + + + Coagulase test + _ _ Mannitol Fermentation + _ _ Colour Gold. Yellow White to Yellow Hemolysis test Beta None Sensitive Resistant Reaction to Novobiocin Sensitive

Streptococci • many streptococcal species are nonpathogenic, and form part of the commensal human microbes of the mouth, skin, upper respiratory tract, intestine and genitourinary tract. • Furthermore, streptococci are a necessary ingredient in producing ("Swiss") cheese. • Many species of streptococcus are responsible of human infection.

Streptococcus pyogens • known as Group A Streptococcus (GAS) is the causative agent in Group A streptococcal infections. • Microscopically appearance: • G+ • Spherical cocci • Arranged in chains of varying length. • Non motile. • Non spore forming. • Non capsulated
• Macroscopically appearance 1 -Cultural characteristic : • Small colonies (pinpoint). • β -hemolysis (complete hemolytic)on blood agar • Semi-transperant. • Low convex
2 -Biochemical tests : • Bile solubility –ve (turbid broth). • Ferment different kind sugar with gas production. • Gelatin hydrolysis : + ve. • Sensitive to bacitracin (antibiotic).

Streptococcus pneumoniae (pneumococcus) • It founds as a normal flora (in 5 -40%) of population but it could cause many diseases e. g. pneumonia , otitis media , sinusitis , bronchitis , meningitis , bacteremia.

• • Microscopically appearance: G+ Spherical diplococci lancet shape Non motile. Non spore forming. capsulated (polysaccharide) so it is highly resistant to phagocytosis , and also according to capsule can be subdivided to specific anti sera-spp.

• Macroscopical appearance 1 -Cultural characteristic : • α -hemolysis (partial hemolytic) on blood agar ( greenish zone around colony). • glistening colonies about 1 mm in diameter. • Colonies appear initially with plateau-type , then start to collapse in the centers when autolysis begins.
Alpha (α) hemolysis (blood agar around bacterial colonies looks greenishbrown, indicating partial breakdown and consumption of hemoglobin) Mixed culture from a throat swab; note several β-hemolytic colonies
• • • 2 -Biochemical tests : Nitrate reduction : – ve. Inulin fermentation : + ve. Capsule reaction (Qulleng reaction): + ve. Bile solubility : + ve ( clear broth ). Optochin (antibiotic) sensitive. o o



Lancefield groupe group Hemolysis Strepto. pyogenes S. pyogenes A A Beta Strepto, agalactiae S. agalactiae B B Beta Str. faecalis S. faecalis (Enterococcus) D D α or β or none Strepto. bovis S. bovis D D α or none α α No growth in 6. 5%Na. Cl Bile soluble Optochin sensitiv α α Bile insoluble Optochin resistan Strepto. pneumoniae S. pneumoniae Not applicable Viridans group Not applicable Diagnostic fetures features Bacitracin Sensitive Bacitracin resistant Growth in 6. 5%Na. Cl

Neisseria • The neisseria is a large genus of commensal bacteria that colonize humans , only two are pathogenic Neisseria Meningitidis , Neisseria gonorrhea , often cause asymptomatic infections. Parasitic bacteria that grow in pairs and occasionally tetrads, thrive best at (37°C) in the animal body or serum media. • N. gonorrhoeae (also called the gonococcus), which causes gonorrhea. • N. meningitidis (also called the meningococcus), one of the most common causes of bacterial meningitis and the causative agent of meningococcal septicaemia.

Microscopically appearance: G -ve, diplococci , kidney shape, non motile, non spore forming and mostly non capsulated.

Macroscopically appearance 1 -Cultural characteristic : Aerobic, prefer (5 -10% CO 2) for primary isolation on enriched media (blood or chocolate). Transparent colonies about 1 -2 mm in diameter, pink convex and mucoid. Selective media for Neisseria is Thyer Martin media (TMM).


2 -Biochemical tests : all Neisseria spp. are Oxidase +ve and Catalase +ve. The differentiation among the Neisseria spp. is based on the sugar fermentation and possession of the DNase , as follows:

Dextrcose Maltose DNase Neisseria gonorrhea (+) (-) Neisseria Meningitidis (+) (-)
- Slides: 30